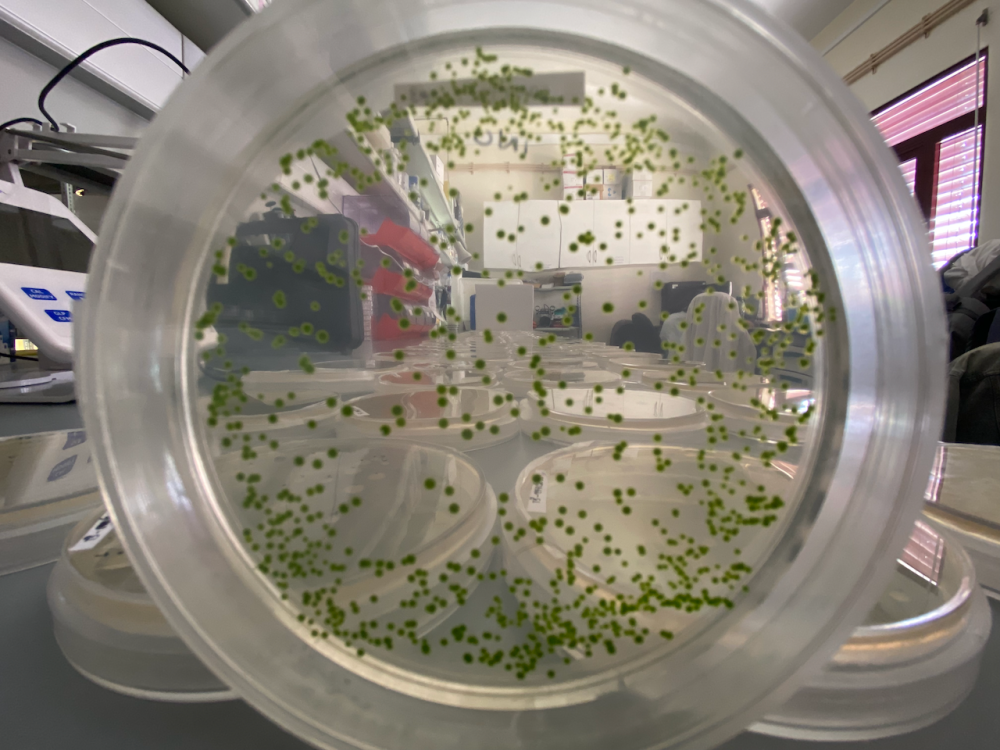
Microalgae

Consulte o meu CV
Grupo
Local de trabalho
CCMAR - Faro (Campus de Gambelas)
Email
tfsantos@ualg.pt
Sobre mim
Marine Biologist holds a master's degree in Aquaculture, where she began her microalgae journey by working with selenium incorporation in the haptophyte Tisochrysis lutea.
She is finishing her Ph.D., which is focused on the characterization and optimization of industrially produced microalgae with a tailor-made microbiome.
Currently, she is a researcher on the Algae Vertical project, where she continues to work with the accompanying microbiome to improve production via alga-microbiome co-cultivation.







